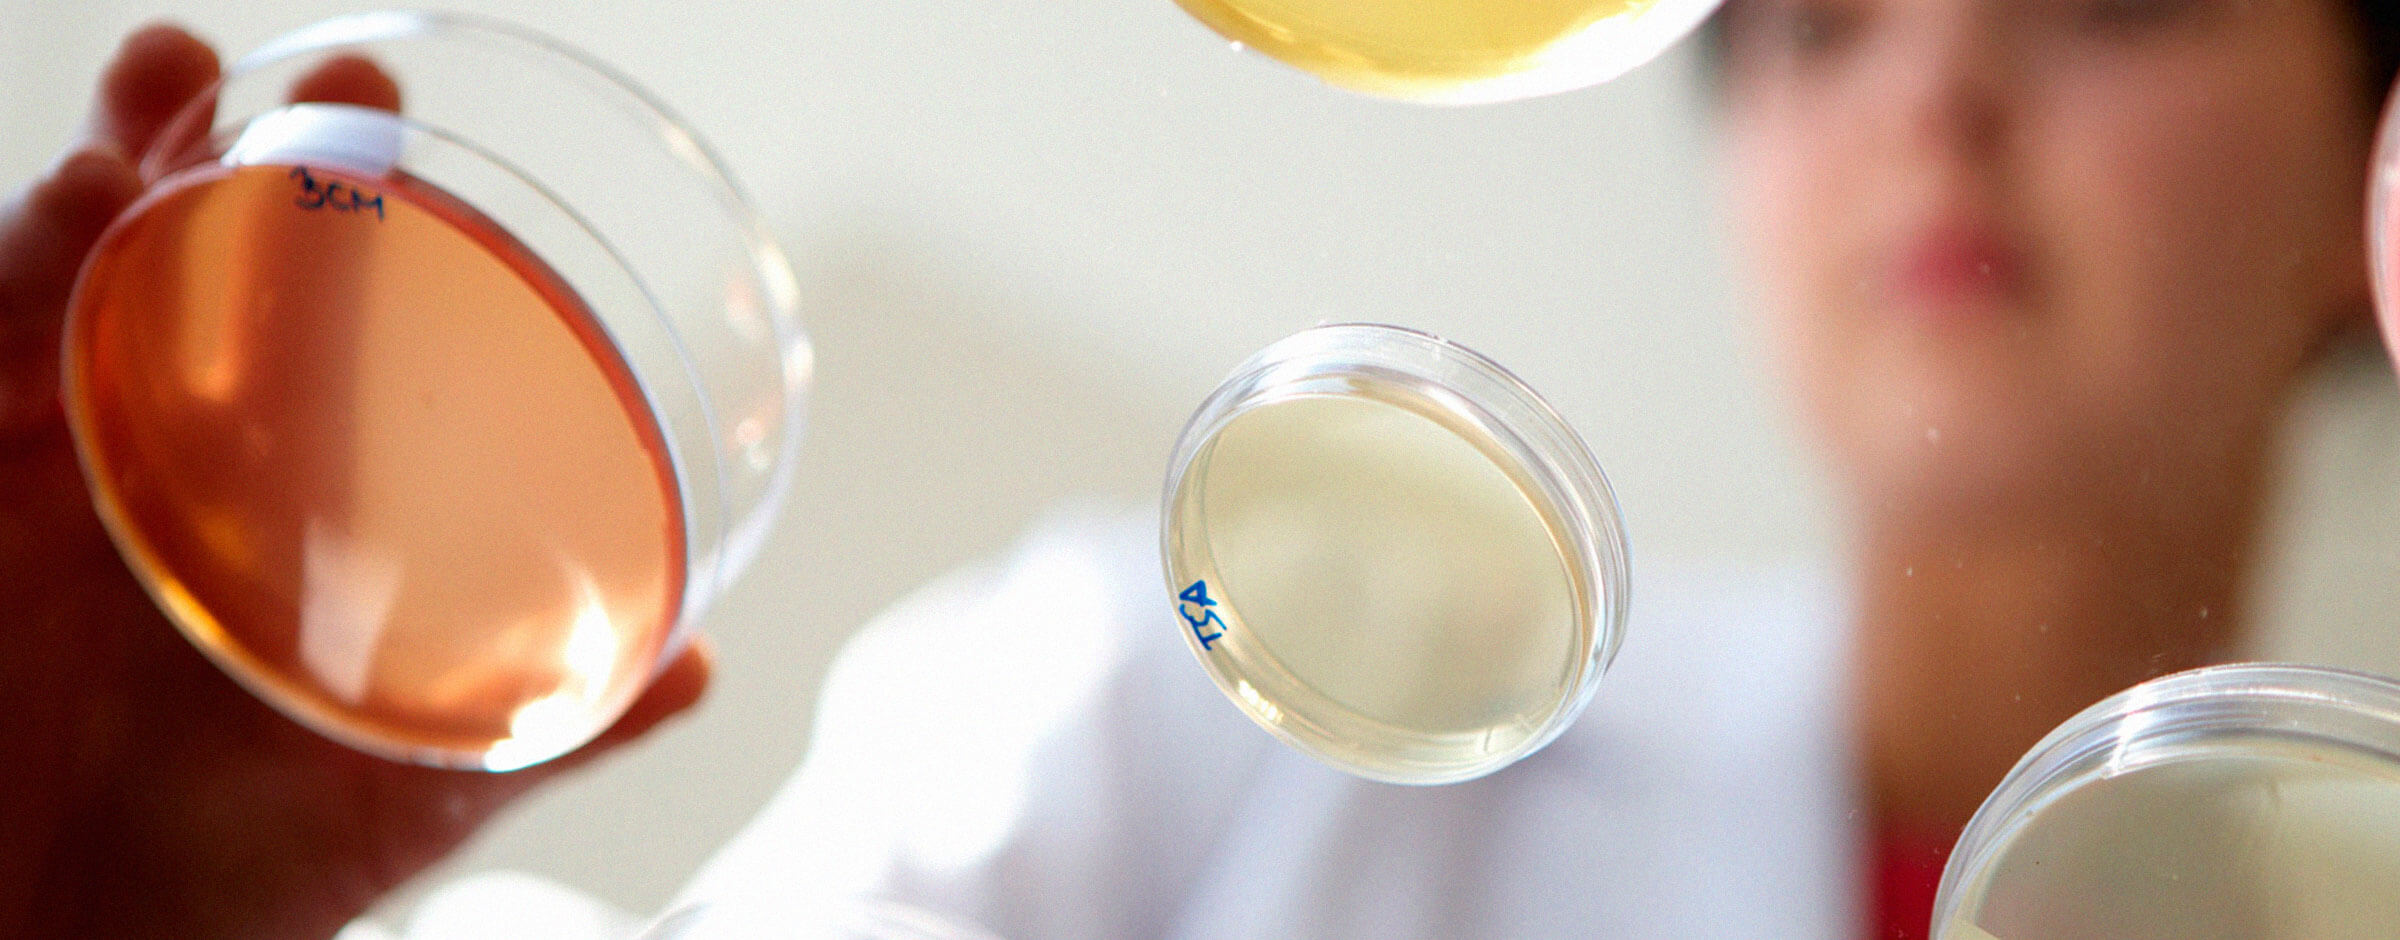
análisis en laboratorio
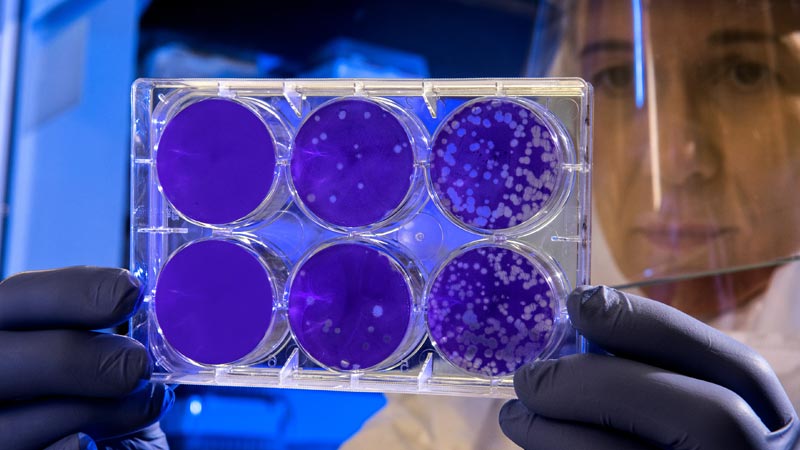
bacteriofagos aplicacion Alimentacion

Calidad, integridad y seguridad alimentaria
Respondemos a las empresas alimentarias en su necesidad de mantener los estándares de calidad requeridos por los y las clientes, diferenciar sus productos y mejorar su posicionamiento en los mercados más exigentes a través de la seguridad alimentaria, control alimentario e identidad alimentaria.
Índice de contenidos
Seguridad alimentaria
Asesoramos a la industria o autoridades de control, anticipándonos incluso a los cambios futuros en las normativas aplicables. Nuestro expertise se centra en: investigación y aplicación de tecnologías y procesos para minimizar los riesgos alimentarios (descontaminación contra las intoxicaciones alimentarias) y el análisis microbiológico; la determinación de la vida comercial de los alimentos (máximo tiempo en el lineal en condiciones óptimas).
Control alimentario
A través de marcadores de calidad y de tecnologías del análisis sensorial que permitan mejorar la aceptación del producto en el mercado.
Identidad alimentaria
Trabajamos con metodologías que permiten asegurar la autenticidad y origen de la materia prima e ingredientes, el cumplimiento de estándares de sostenibilidad, así como la verificación de procesos y la legislación del etiquetado vigente: alegaciones de origen, certificaciones, acreditaciones y sellos de identidad.
Somos especialistas en control y minimización de los riesgos físicos, químicos y biológicos de los alimentos; aceptación del producto en el mercado, análisis sensorial; autenticidad y origen de la materia prima e ingrediente; mayor vida media en el lineal; sensórica e sistemas inteligentes de control
Nuestro personal investigador es experto en el desarrollo y validación de:
- Kits, sensores y metodologías para la detección de contaminantes biológicos y químicos (pesticidas, patógenos, alérgenos) así como la validación de las metodologías comerciales.
- Sistemas inteligentes (etiquetas, sensores, etc.) para la evaluar la trazabilidad en la cadena de distribución de alimentos.
- Métodos para la autentificación de especies o sus mezclas, alimentos, materias primas (pescado, carne, vegetales, fruta, conservas, zumos, surimi, etc.), procesos alimentarios o estándares de sostenibilidad.
- Métodos alternativos para evaluar la toxicidad de nuevos componentes alimentarios y posibles contaminantes alimentarios y sus mezclas.
- Alimentos con riesgos biológicos y químicos reducidos (hipoalergénicos, bajos en sal, grasas, etc.) mediante el uso de nuevas tecnologías.
- Sistemas de gestión para el autocontrol de la calidad y la autenticidad.
En el ámbito de la calidad, seguridad e identidad alimentaria abarcamos todas las fases productivas (materias primas, producción y producto final) y para un amplio número de empresas y sectores:
- Empresas desarrolladoras y distribuidoras de kits para evaluar de un modo más rápido, económico y eficaz los desafíos en calidad y seguridad alimentaria de la industria alimentaria.
- Empresas de ingredientes y suplementos nutricionales para validar la calidad, identidad e integridad de sus materias primas y productos así como su la inocuidad.
- Laboratorios analíticos, gran distribución alimentaria, operadores logísticos y Canal HORECA para diseñar, desarrollar y validar nuevas metodologías de trazabilidad o autentificación de alimentos y materias primas que puedan ser implementados en el futuro en dichas industrias.